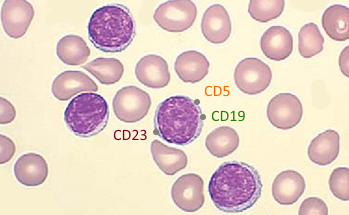

Хронический лимфолейкоз
Хронический лимфолейкоз (ХЛЛ) — злокачественное лимфопролиферативное заболевание, в основе которого лежит накопление моноклональных В-лимфоцитов зрелой морфологии, имеющих характерный аберрантный иммунофенотип.
ХЛЛ является наиболее распространенным вариантом лейкоза в РФ, США и Европе, но редко встречается в странах Восточной Азии. Болеют ХЛЛ преимущественно люди пожилого возраста, ежегодно регистрируются 3-5 случаев заболевания на каждые 100 тысяч человек. Болезнь проявляется увеличением количества лимфоцитов в крови и костном мозге, увеличением размеров лимфатических узлов, печени и селезенки, аутоиммунными осложнениями и иммунодефицитом. Выживаемость в течение 5 лет у пациентов, получающих современную терапию, превышает 90%. При этом клиническое течение ХЛЛ гетерогенно и зависит от биологических особенностей опухоли у конкретного пациента.
ХЛЛ является удобной моделью для исследования патогенеза лимфопролиферативных заболеваний и онкогенеза в целом. Научные интересы НИЛ онкогематологии лежат в области изучения механизмов устойчивости клеток ХЛЛ к новым таргетным препаратам – ингибиторам белков Bcl-2 и Btk, а также создания новых вариантов клеточной терапии этого заболевания. В рамках государственного задания 2018—2020 гг проводится оценка динамики клона с мутациями TP53 как прогностического маркера развития резистентности к новым ингибиторам. Для этого анализируется доля клеток с del (17p) по данным FISH-анализа в сепарированных лейкозных клетках, полученных из периферической крови.
![]() |
![]() |
![]() |
С 2019 г инициировано наблюдательное исследование IB-RU-SCOPE (NCT03633045), в котором изучается безопасность и эффективность ибрутиниба при лечении больных ХЛЛ в условиях отечественной клинической практики. Участие в исследовании принимают врачи-гематологи в различных регионах РФ. Всего до 2023 г. планируется включить 70 пациентов.
Сотрудники НИЛ онкогематологии принимают активное участие в обновлении российских клинических рекомендации по терапии больных ХЛЛ, работе экспертных советов, клинических исследованиях новых препаратов, обучении врачей-гематологов из регионов РФ.